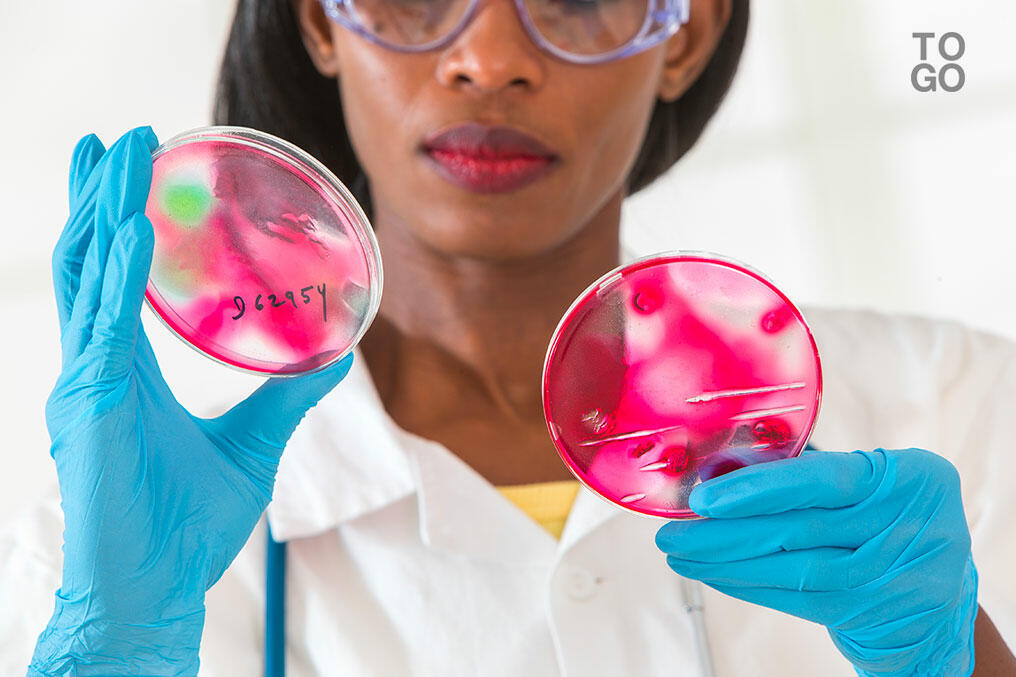

- Diplomatie
Un atelier d'élaboration du Plan d'Action National (PAN) dans le cadre de l'initiative des centres d'excellence NRBC de l'Union européenne, s’est ouvert ce matin à Lomé.
Cette initiative de l’UE pour la réduction des risques chimiques, biologiques, radiologiques et nucléaires (NRBC) a pour objectif la réduction des risques et la préparation à ces événements.
L’origine peut être criminelle (prolifération, vol, sabotage et trafic illicite), accidentelle (catastrophes industrielles, notamment chimiques ou nucléaires, traitement des déchets, transport) ou naturelle (principalement les pandémies, mais aussi les conséquences des risques naturels sur du matériel et des installations chimiques ou biologiques.
Dans ce projet, le concept de gouvernance repose sur la nécessité pour l'initiative de se traduire par des projets stratégiques et efficaces, sur une gestion fiable et des résultats concrets ; une planification stratégique, une capacité de mise en œuvre, une capacité à résoudre des problèmes, une application de standards techniques NRBC, une réelle coordination inter-agences et une coopération entre les pays doivent être menées.
Les partenaires doivent travailler sur la base d’une approche consensuelle, en appliquant des techniques de communication et de médiation, en impliquant la société civile, en prenant en compte les différentes sensibilités et en accord avec une culture de l’évaluation.
Le réseau des centres d’excellence NRBC comprend 58 pays à travers le monde. Ils sont regroupés autour de bureaux régionaux, celui de la façade atlantique africaine (10 Etats) auquel le Togo est rattaché est hébergé par le Maroc.
Dans le cadre du NRBC, le Togo participe à un projet visant à l'amélioration de la gestion des épidémies dans les pays partenaires de la façade atlantique africaine et à un projet concernant l'atténuation des risques des installations chimiques classées dans cette même région.
Le pays sera associé au prochain projet régional sur le transport des matières dangereuses puis il bénéficiera d’un soutien financier pour l’amélioration de la sécurité sanitaire des aliments.





